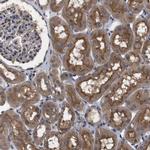
ARHGAP24 Antibody in Immunohistochemistry (IHC)

Search
Invitrogen
ARHGAP24 Polyclonal Antibody
{{$productOrderCtrl.translations['antibody.pdp.commerceCard.promotion.promotions']}}
{{$productOrderCtrl.translations['antibody.pdp.commerceCard.promotion.viewpromo']}}
{{$productOrderCtrl.translations['antibody.pdp.commerceCard.promotion.promocode']}}: {{promo.promoCode}} {{promo.promoTitle}} {{promo.promoDescription}}. {{$productOrderCtrl.translations['antibody.pdp.commerceCard.promotion.learnmore']}}
产品信息
PA5-53140
种属反应
宿主/亚型
分类
类型
抗原
偶联物
形式
浓度
规格
纯化类型
保存液
内含物
保存条件
运输条件
RRID
产品详细信息
Immunogen sequence: ILNSDTLGNP TNVRNMSWLP NGYVTLRDNK QKEQAGELGQ HNRLSTYDNV HQQFSMMNLD DKQSIDSATW STSSCEISLP ENSNSCRSST TTCPEQDFFG GNFEDPVLDG PPQDDLSHPR DYESKSD
Highest antigen sequence identity to the following orthologs: Mouse - 88%, Rat - 90%.
靶标信息
Rho GTPase-activating protein involved in cell polarity, cell morphology and cytoskeletal organization. Acts as a GTPase activator for the Rac-type GTPase by converting it to an inactive GDP-bound state. Controls actin remodeling by inactivating Rac downstream of Rho leading to suppress leading edge protrusion and promotes cell retraction to achieve cellular polarity. Able to suppress RAC1 and CDC42 activity in vitro. Overexpression induces cell rounding with partial or complete disruption of actin stress fibers and formation of membrane ruffles, lamellipodia, and filopodia. Isoform 2 is a vascular cell-specific GAP involved in modulation of angiogenesis.
仅用于科研。不用于诊断过程。未经明确授权不得转售。
篇参考文献 (0)
生物信息学
蛋白别名: Filamin-A-associated RhoGAP; FilGAP; p73RhoGAP; RAC1- and CDC42-specific GTPase-activating protein of 72 kDa; RC-GAP72; Rho GTPase-activating protein 24; Rho-type GTPase-activating protein 24; RhoGAP of 73 kDa; Sarcoma antigen NY-SAR-88; unnamed protein product
基因别名: ARHGAP24; FILGAP; p73; p73RhoGAP; RC-GAP72; RCGAP72
UniProt ID: (Human) Q8N264
Entrez Gene ID: (Human) 83478